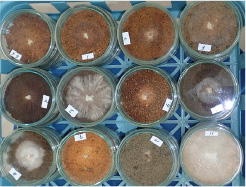
mycelial germination test

Bringing High-quality ‘Japan-made Mushroom’ to Dining Tables around the World
HOKKEN CO., LTD. is a global comprehensive mushroom company specializing in every aspect of mushroom production, from designing and constructing facilities required for cultivation to providing mushroom varieties, equipment, and materials, as well as offering cultivation consulting. Our strength lies in our exceptional ability to develop superior mushroom varieties, our technology to stabilize the performance of the varieties, and our innovative capabilities to create new cultivation methods. As a 'Japan-made' brand, we support mushroom producers worldwide with top-quality varieties and advanced cultivation techniques. If you are interested in mushroom production or have any inquiries, please free to contact us.
Our Strengths
One of our Clients’ Shiitake Factory
This shiitake mushroom factory is one of our clients’. This factory was converted from a Phalaenopsis orchid farm and has been in operation since 2024. The facility can produce up to 5.376 cultivation blocks per day (2,688 blocks × 2 rotations). It is a fully automated production line, requiring only one operator.
For Newcomers to Mushroom Cultivation
We provide comprehensive consulting services, from testing the suitability of mushroom varieties that are locally available, to facility planning, mushroom production, and sales, to help you get your business on track.
We offer design proposal for mushroom bed production line from small scale to large scale
There are different types of trees that are compatible with different types of varieties of mushrooms. We will help you make your mushroom business successful by proposing the right kinds of trees and mushroom varieties that are available locally.
mycelial germination test
For Existing Mushroom Growers
We can help you improve your business by introducing mushroom varieties developed by Hokken and provide cultivation services to improve mushroom quality and yield. We also propose labor-saving mushroom cultivation equipment and materials according to the scale of cultivation.





